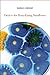
Debt to the Bone-Eating Sno...

| 1 |

|
Autobiography of Red
by
4.25 avg rating — 37,512 ratings
Kate
rated it 5 stars
See Review
|
|
| 2 |

|
What Is This Thing Called Love: Poems
by
4.11 avg rating — 1,617 ratings
Kate
rated it 5 stars
See Review
|
|
| 3 |

|
New and Selected Poems, Vol. 2
by
4.56 avg rating — 3,950 ratings
Kate
rated it 5 stars
See Review
|
|
| 4 |

|
Satan Says (Pitt Poetry Series)
by
4.21 avg rating — 2,528 ratings
Kate
rated it 5 stars
See Review
|
|
| 5 |

|
Kinky
by
4.26 avg rating — 494 ratings
Kate
rated it 5 stars
See Review
|
|
| 6 |

|
Facts About the Moon
by
4.30 avg rating — 920 ratings
Kate
rated it 5 stars
See Review
|
|
| 7 |

|
What the Living Do: Poems
by
4.32 avg rating — 5,336 ratings
Kate
rated it 5 stars
See Review
|
|
| 8 |

|
Scattered at Sea
by
3.76 avg rating — 304 ratings
Kate
rated it 5 stars
See Review
|
|
| 9 |

|
How to Be Drawn
by
4.18 avg rating — 1,102 ratings
Kate
rated it 5 stars
See Review
|
|
| 10 |

|
Motherland Fatherland Homelandsexuals
by
3.77 avg rating — 2,845 ratings
Kate
rated it 5 stars
See Review
|
|
| 11 |

|
Brain Fever: Poems
by
3.76 avg rating — 95 ratings
Kate
rated it 5 stars
See Review
|
|
| 12 |

|
If the Tabloids Are True What Are You?
by
4.18 avg rating — 364 ratings
Kate
rated it 5 stars
See Review
|
|
| 13 |
|
Debt to the Bone-Eating Snotflower
by
4.20 avg rating — 44 ratings
Kate
rated it 5 stars
See Review
|
|
| 14 |

|
Scary, No Scary
by
4.24 avg rating — 811 ratings
Kate
rated it 5 stars
See Review
|
|
| 15 |

|
Unincorporated Persons in the Late Honda Dynasty
by
4.07 avg rating — 861 ratings
Kate
rated it 5 stars
See Review
|
|
| 16 |

|
I Have to Go Back to 1994 and Kill a Girl: Poems
by
4.04 avg rating — 421 ratings
Kate
rated it 5 stars
See Review
|
|
| 17 |

|
Picnic, Lightning
by
4.27 avg rating — 4,543 ratings
Kate
rated it 5 stars
See Review
|
|
| 18 |

|
The Voice At 3:00 A.m.: Selected Late and New Poems – A National Book Award Nominee's Brilliant Imagery and Sardonic Wit
by
4.09 avg rating — 903 ratings
Kate
rated it 5 stars
See Review
|
|
| 19 |

|
Flying At Night: Poems 1965-1985 (Pitt Poetry Series)
by
4.19 avg rating — 606 ratings
Kate
rated it 5 stars
See Review
|
|
| 20 |

|
The Apple Trees at Olema: New and Selected Poems
by
4.28 avg rating — 510 ratings
Kate
rated it 5 stars
See Review
|
|
| 21 |

|
School of the Arts
by
3.88 avg rating — 326 ratings
Kate
rated it 5 stars
See Review
|
|
| 22 |

|
Space, in Chains
by
4.07 avg rating — 696 ratings
Kate
rated it 5 stars
See Review
|
|
| 23 |

|
, said the shotgun to the head.
by
4.21 avg rating — 3,238 ratings
Kate
rated it 5 stars
See Review
|
|
| 24 |

|
The Executive Director of the Fallen World
by
4.33 avg rating — 58 ratings
Kate
rated it 5 stars
See Review
|
|
| 25 |

|
Unmentionables: Poems
by
3.87 avg rating — 254 ratings
Kate
rated it 5 stars
See Review
|
|
| 26 |

|
The Floating Bridge (Pitt Poetry Series)
by
4.04 avg rating — 71 ratings
Kate
rated it 5 stars
See Review
|
|
